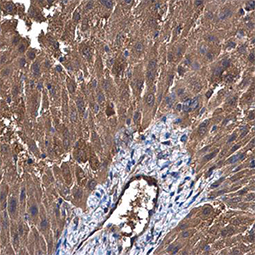
UGP2 antibody (GTX107967)

![]() |
Glycogenolysis is the breakdown of glycogen branches through catabolic reactions via the sequential removal of glucose monomers via phosphorolysis, catalyzed by the enzyme glycogen phosphorylase. Glycogen is cleaved from glycogen (n) to produce glucose-1-phosphate and glycogen (n-1). Phosphoglucomutase (PGM) then converts glucose-1-phosphate into glucose-6-phosphate, which then enters the glycolytic pathway. Glycogenolysis takes place in muscle and liver cells in response to hormonal (i.e., glucagon, insulin, and epinephrine) and neural signals
Glycogenesis, in contrast, is the process of anabolic synthesis of glycogen. Glucose molecules are phosphorylated to glucose-6-phosphate, converted to glucose-1-phosphate and UDP-glucose, and added to glycogen chains for storage.
|
Highlighted Products |
|
|
|
|
||||||||||||||||